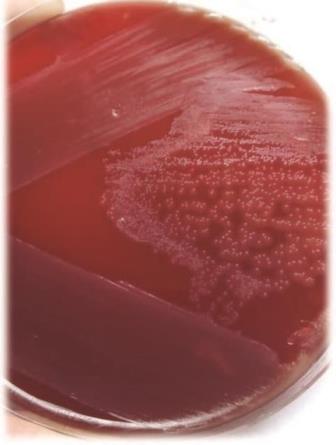

MICROBIOLOGÍA
Rol de los estreptococos del grupo Streptococcus anginosus en infecciones de piel y partes blandas: reporte de 3 casos
Role of Streptococcus anginosus group streptococci in skin and soft tissue infections: report of 3 cases
Papel dos estreptococos do grupo Streptococcus anginosus em infecções na pele e partes brandas: reporte de 3 casos
Homenaje a la trayectoria del Prof. Dr. Daniel Mazziotta†
Rol de los estreptococos del grupo Streptococcus anginosus en infecciones de piel y partes blandas: reporte de 3 casos
Acta Bioquímica Clínica Latinoamericana, vol. 53, núm. 4, pp. 545-549, 2019
Federación Bioquímica de la Provincia de Buenos Aires
Recepción: 02 Mayo 2019
Aprobación: 27 Junio 2019
Resumen: Los estreptococos del grupo Streptococcus anginosus (GSA) comprenden uno de los grupos que conforman el grupo viridans de estreptococos y son parte de la microbiota humana habitual de la cavidad oral, del tracto respiratorio superior y del tracto gastrointestinal. Pueden producir colecciones purulentas de órganos sólidos, abscesos cutáneos y celulitis, entre otras infecciones. Este grupo posee numerosos factores de virulencia como hialuronidasa, adhesinas, enzimas extracelulares y hemolisinas. El objetivo de este trabajo fue presentar tres casos clínicos de infecciones asociadas a traumatismos vinculados con la cavidad oral como golpes de puño o mordeduras humanas. En todos ellos, los GSA desarrollaron como germen único, lo que pone de manifiesto su importante rol en este tipo de infecciones.
Palabras clave: Streptococcus anginosus, Infecciones de piel y partes blandas, Traumatismo de la cavidad oral, Mordeduras humanas, Golpe de puño.
Abstract: The Streptococcus anginosus group (SAG) is part of the viridans group streptococci and they belong to the normal human microbiota of the oral cavity, the upper respiratory tract and the gastrointestinal tract. It can produce purulent collections of solid organs, cutaneous abscesses and cellulitis, among other infections. This group has numerous virulence factors such as hyaluronidase, adhesins, extracellular enzymes and hemolysins. The objective of this work is to present three clinical cases of infections associated with trauma related to the oral cavity such as fist bumps or human bites. In all of them, the SAG developed as a single organism, which highlights its important role in this type of infection.
Keywords: Streptococcus anginosus, Skin and soft tissue infections, Trauma of the oral cavity, Human bites, Fist bump.
Resumo: Os estreptococos do grupo do Streptococcus anginosus (GSA) são parte de um dos grupos que constituem o grupo viridans e fazem parte da microbiota normal da cavidade oral, do trato respiratório superior e do trato gastrointestinal dos seres humanos. Podem produzir coleções purulentas de órgãos sólidos, abscessos cutâneos e celulite, entre outras infecções. Este grupo possui numerosos fatores de virulência, como hialuronidases, adesinas, enzimas extracelulares e hemolisinas. O objetivo desse trabalho foi apresentar três casos clínicos de infecções associadas a traumatismos associados à cavidade oral, decorrentes de socos ou mordidas humanas. Em todos eles os GSA se desenvolveram como germe único, o que põe de manifesto seu papel importante nesse tipo de infecções.
Palavras-chave: Streptococcus anginosus, Infecções na pele e tecidos moles, Traumatismo da cavidade oral, Mordidas humanas, Soco.
Introducción
Los estreptococos del grupo Streptococcus anginosus (GSA), también llamados estreptococos del grupo “Streptococcus milleri”, son frecuentemente referidos como miembros del grupo viridans, a pesar de su variabilidad en la actividad hemolítica. Este grupo está conformado por tres especies: treptococcus intermedius, Streptococcus anginosus. Streptococcus constellatus. Entre 1999 y 2013, se describieron cinco subespecies, tres pertenecientes a la especie Streptococcus constellatus y dos a Streptococcus anginosus. Streptococcus constellatus subsp. constellatus, Streptococcus constellatus subsp. pharyngis, Streptococcus constellatus subsp. viborgensis, streptococcus anginosus subsp. anginosus y Streptococcus anginosus subsp. whileyi (1) (2).
Son microorganismos anaerobios facultativos y algunas cepas crecen mejor en atmósfera enriquecida en CO. y/o disminuída en oxígeno (3). Desarrollan en medios sólidos formando colonias puntiformes de no más de 0,5 mm de diámetro, que pueden presentar hemólisis de tipo alfa, beta o gamma y que poseen un fuerte olor a caramelo debido a la producción de diacetilo (4). Según la clasificación de Lancefield la mayor parte de las cepas presenta el polisacárido de pared del grupo F, pero algunas aglutinan en forma cruzada con los antisueros A, C, G o bien son “no seroagrupables”.
Los GSA forman parte de la microbiota habitual de la cavidad oral humana, del tracto respiratorio superior y del tracto gastrointestinal. No obstante, son agentes causales de colecciones purulentas de diversos tipos como abscesos cutáneos y celulitis y su vía de infección es la hematógena o bien es producida mediante traumatismos. Por otro lado se describieron en periodontitis, abscesos odontogénicos y sinusitis (5). Se ha valorizado su rol en exacerbaciones bronquiales en pacientes con fibrosis quística (6). Algunos autores establecieron una asociación entre las especies de este grupo y ciertas localizaciones de las infecciones: S. intermedius en abscesos cerebrales y hepáticos, S. constellatus en empiemas, por complicaciones de neumonías adquiridas en la comunidad y S. anginosus en infecciones urogenitales, gastrointestinales, tejidos blandos, bacteriemias, endocarditis y abscesos ocultos (7).
Se describieron algunos factores de virulencia asociados a GSA, entre ellos una adhesina no fibrilar, la enzima hialuronidasa, su cápsula polisacárida, enzimas extracelulares que degradan tejido conectivo y en el caso de S. intermedius una hemolisina llamada intermedilisina (8).
De las especies que componen el grupo la más virulenta parece ser S. intermedius, ya que posee varios factores de patogenicidad además de la intermedilisina, entre ellos una sialidasa, encontrada solamente en esta especie (5). Más aún, se ha descripto una cepa hipervirulenta de S. intermedius (9).
Los GSA presentan muy bajos niveles de CIM de penicilina, por lo que son los estreptococos de mayor sensibilidad a dicho antibiótico dentro del grupo viridans, tanto in vitro como in vivo, los cuales se han mantenido estables en el tiempo (10). La penicilina ha sido el agente antimicrobiano de elección frente a estos microorganismos. La falta de sensibilidad a la penicilina de algunas cepas está relacionada con la mutación en genes que codifican proteínas ligadoras de penicilina (PBP).
La resistencia a eritromicina y clindamicina que era nula en la década de los 80, llegó más tarde a alcanzar porcentajes que van del 0 a más del 50% especialmente en cepas obtenidas de pacientes con fibrosis quística (11).
La resistencia a vancomicina es prácticamente inexistente entre los GSA; sin embargo, se describió una cepa portadora del gen vanG proveniente de una muestra de orina (12).
Es importante resaltar que los estreptococos del grupo viridans son posibles reservorios de genes de resistencia con posibilidad de transferencia de la misma a otros estreptococos orales.
El objetivo de este trabajo fue presentar tres casos clínicos para destacar el rol patógeno de los GSA en las infecciones de piel y tejidos blandos.
Presentación de los casos
Caso clínico 1
Se trató de un paciente de sexo masculino, de 26 años de edad, que consultó a la Guardia del hospital por tumefacción del dedo pulgar izquierdo. Refirió haber recibido una mordedura humana 30 días atrás en dicha zona. La radiografía evidenció una lesión osteolítica en la falange distal compatible con osteomielitis. El paciente no presentaba antecedentes de relevancia clínica.
Se realizó drenaje de la herida, cultivo del material y comenzó con un tratamiento antibiótico empírico con una droga que el paciente no recordaba. En la tinción de Gram de la muestra se observaron abundantes leucocitos y cocos gram positivos en cadena. En el cultivo desarrolló S. intermedius como germen único. No presentaba beta-hemólisis en agar sangre ovina al 5%. Este microorganismo presentaba sensibilidad in vitro a penicilina, cefotaxima, eritromicina, clindamicina y levofloxacina. Se desconoce su evolución clínica.
Caso clínico 2
Un paciente de sexo masculino, de 27 años de edad, consultó al Servicio de Cirugía Maxilofacial del hospital por aumento de volumen facial izquierdo de 4 días de evolución. Como antecedente, refería haber recibido un trauma en dicha región producido durante un episodio de violencia vinculado a su estado de ebriedad. Al examen clínico se evidenció un aumento del volumen de la región para y submandibular izquierda, induración, dolor a la palpación, ligera limitación a la apertura bucal, disfagia en la alimentación y fístula mandibular izquierda asociada a fractura de mandíbula. Como antecedente de importancia clínica refirió ser adicto a la cocaína.
Se realizó una punción aspiración de la colección y se administró tratamiento analgésico y antibiótico con clindamicina (600 mg cada 6 horas). El paciente evolucionó favorablemente.
En la coloración de Gram de la muestra clínica se observó una regular cantidad de leucocitos pero no se observaron bacterias. En el cultivo desarrolló S. intermedius, sin beta-hemólisis en agar sangre ovina al 5%, sensible a penicilina y cefotaxima.
Caso clínico 3
Se trató de un paciente de sexo masculino, de 27 años de edad, que consultó al Departamento de Urgencias por fiebre de 24 horas de evolución y empeoramiento de una lesión en la mano derecha. Al examen clínico se constató la presencia de un absceso en dicha mano y celulitis en antebrazo correspondiente. El paciente refirió que la lesión fue provocada por un “golpe de puño” que el mismo había proferido y que había impactado en la boca de otra persona. Como antecedentes de relevancia clínica refirió ser diabético tipo I, dependiente de insulina.
Se internó con tratamiento endovenoso con ciprofloxacina (200 mg c/12 horas) y clindamicina (600 mg cada 6 horas), se realizó una toilette quirúrgica y se envió material del absceso para cultivo. En el cultivo desarrolló S. constellatus (identificación presuntiva por métodos fenotípicos), sin beta- hemólisis en agar sangre ovina al 5%, sensible a penicilina, cefotaxima, eritromicina, clindamicina y levofloxacina. El paciente evolucionó favorablemente.
Materiales y Métodos
Datos de los pacientes
Con el objetivo de extraer datos clínicos y epidemiológicos relevantes se revisaron las historias clínicas de los tres pacientes en los archivos pertenecientes al Hospital Gral. de Agudos P. Piñero y al Hospital Nacional B. Sommer.
Procesamiento de las muestras
Todas las muestras fueron obtenidas por punción aspiración, se realizó coloración de Gram y se sembraron en agar sangre de carnero al 5% y agar chocolate incubados a 37 ºC en atmósfera con 5% de CO2, en agar CLDE y caldo tioglicolato, incubados a 37 ºC en atmosfera normal y en agar chocolate incubado en atmósfera anaeróbica a 37 ºC.
Identificación
Se realizó coloración de Gram de las colonias e identificación mediante equipo automatizado Vitek 2C (bioMérieux, Argentina) y espectrometría de masa utilizando Vitek MS (bioMérieux, Argentina) para los aislamientos de los casos clínicos número 1 y 2. En el caso clínico número 3 se utilizaron para la identificación pruebas bioquímicas convencionales como: bilis esculina, pirrolidonil arilamidasa (PYR), leucinamino peptidasa (LAP), cloruro de sodio al 6,5%, hemólisis y olor, además de métodos miniaturizados (API 20 Strep® bio-Mérieux, Argentina) y equipo automatizado Vitek 2C.
La cepa 1 originalmente no presentaba hemólisis en agar sangre ovina. Para poder observar la beta-hemólisis en sangre humana, característica de la intermedilisina (9), se preparó una placa con una base inferior de agar Columbia y una capa superior de 3 mL de agar Columbia con el agregado de 0,5 mL de sangre humana. Se estrió la placa con la cepa en estudio y se incubó durante 48 h a 35 ºC en atmósfera con 5% de CO. (Fig.1).
Pruebas de sensibilidad a los antibióticos
Se realizaron pruebas de sensibilidad a cuatro antimicrobianos (cefotaxima, clindamicina, eritromicina y levofloxacina) utilizando el método de difusión con discos en agar Mueller-Hinton con 5% de sangre ovina según recomendaciones del CLSI (13). La concentración inhibitoria mínima de pencilina se determinó por Etest (bioMérieux, Argentina), en las mismas condiciones.
Figura 1
Figura 1
Discusión y Conclusiones
Las mordeduras producidas por seres humanos representan del 3 al 4% de todas las mordeduras y se clasifican en:
1. Autoagresión: son heridas superficiales asociadas a paroniquia.
2. Lesión oclusiva: el agresor clava voluntariamente los dientes en la víctima. Suele producirse en peleas o durante relaciones sexuales (caso 1).
3. Mordedura del puño del agresor: heridas ocasionadas en el puño cerrado de un agresor que impacta sobre los dientes de la víctima (caso 3) (14). Las infecciones producidas por mordedura humana y por golpe de puño en la cavidad oral son en general polimicrobianas e involucran agentes etiológicos de la microbiota oral (14).
La cavidad oral contiene diversos microambientes o nichos que permiten el desarrollo de abundantes y diversas bacterias, condicionadas por factores anatómicos, físicos y químicos (15).
Si bien se han descripto diferentes especies, tanto de microorganismos aerobios como anaerobios, existe un predominio del género Streptococcus, y particularmente los GSA representan entre el 30 y el 60 % de la microbiota de la cavidad oral. Estos microorganismos tienen una distribución heterogénea según la zona de la boca y, desde allí, pueden colonizar la piel de manera transitoria o desarrollar infecciones en calidad de oportunistas.
Los GSA son frecuentemente aislados de mordeduras humanas infectadas y debido a los factores de virulencia que poseen pueden causar infecciones complicadas como osteomielitis, artritis y tenosinovitis (15).
Los tres pacientes presentados poseen como característica común haber recibido un trauma vinculado con la cavidad oral (mordedura humana o golpe de puño), y desarrollaron posteriormente una infección por GSA como germen único.
Conocer la etiología de las infecciones por mordeduras y golpes de puño humano permite seleccionar un tratamiento empírico adecuado. En este sentido amoxicilina-ácido clavulánico, clindamicina + trimetroprima sulfametoxazol o clindamicina + fluoroquinolonas constituyen las mejores alternativas terapéuticas (14).
Este trabajo pone en evidencia la capacidad patogénica de este grupo de microrganismos y su rol dentro de las infecciones de piel y tejidos blandos. Por otro lado es importante la correcta identificación, dentro de los estreptococos del grupo viridans, a nivel de especie o al menos a nivel de grupo, debido a que muchas veces se desestiman como contaminantes en infecciones de piel y partes blandas que pueden llegar a ser complicadas.
Referencias bibliográficas
1. Whiley RA, Hall LM, Hardie JM, Beighton DM. A study of small-colony, beta-hemolytic, Lancefield group C streptococci within the anginosus group: description of Streptococcus constellatus subsp. pharyngis subsp. nov. associated with the human throat and pharyngitis. Int J Syst Bacteriol 1999; 49: 1443-9.
Jensen A, Hoshino T, Kilian M. Taxonomy of the anginosus group of the genus Streptococcus and description of Streptococcus anginosus subsp. whileyi subsp. nov. and Streptococcus constellatus subsp. viborgensis subsp. nov. Int J Syst Evol Microbiol 2013; 63(Pt 7): 2506-19.
3. Sisson PR, Ingham HR, Selkon JB. A study of carbon dioxide-dependent strains of Streptococcus milleri. J Med Microbiol 1978; 11: 111-6.
4. Brogan O, Malone J, Fox C, Whyte AS. Lancefield grouping and smell of caramel for presumptive identification and assessment of pathogenicity in the Streptococcus milleri group. J Clin Pathol 1997; 50: 332-5.
5. Gray T. Streptococcus anginosus group: clinical significance of an important group of pathogens. Clin Microbiol Newsl 2005; 27: 155-9.
6. Parkins MD, Sibley CD, Surette MG, Rabin HR. The Streptococcus milleri group-an unrecognized cause of disease in cystic fibrosis: a case series and literature review. Pediatr Pulmonol 2008; 43: 490-7.
7. Whiley RA, Beighton D, Winstanley TG, Fraser HY, Hardie JM. S. intermedius, S. constellatus, and S. anginosus (“Streptococcus milleri group”): association with different body sites and clinical infections. J Clin Microbiol 1992; 30: 243-4.
8. Nagamune H, Ohnishi C, Katsuura A, Fushitani K, Whiley RA, Tsuji A, et al. Intermedilysin, a novel cytotoxin specific for human cells secreted by Streptococcus intermedius UNS46 isolated from a human liver abscess. Infect Immun 1996; 64: 3093-100.
9. Tomoyasu T, Matoba M, Takao A, Tabata A, Whiley RA, Maeda N, et al. Rapid screening method for detecting highly pathogenic Streptococcus intermedius strains carrying a mutation in the lacR gene. FEMS Microbiol Lett 2018 Feb 1; 365 (3). doi: 10.1093/femsle/fnx258.
10. Suzuk S, Kaskatepe B, Cetin M. Antimicrobial susceptibility against penicilllin, ampicilin and vancomycin group Streptococcus in oral microbiota of patients at risk of infective endocarditis. Infez Med 2016; 24: 190-3.
11.Grinwis ME, Sibley CD, Parkins MD, Esnaghurshan CS, Rabin HR, Surette MG. Macrolide and clindamycin resistance in Streptococcus milleri group isolates from the airways of cystic fibrosis patients. Antimicrob Agents Chemother 2010; 54: 2823-9.
12. Srinivasan V, Metcalff BJ, Knipe KM, Otawa M, McGee L, Shewmaker PL, et al. vanG element insertions withins a conserved chromosomal site conferring vancomycin resistance to Streptococcus agalactiae and Streptococcus anginosus. mBIO 2014; 5: e01386-13.
13. Clinical and Laboratory Standards Institute Performance Standards of Antimicrobial Susceptibility Testing. 29th ed. CLSI Suplement M100. Wayne, PA: Clinical and Laboratory Standards Institute, 2019.
14. Lopardo H. Microbiología de las infecciones posteriores a mordeduras. Med Infant 2018: 24: 38-45.
15. Talan DA, Abrahamian FM, Moran GJ, Citron DM, Tan JO, Goldstein EJ, et al. Clinical presentation and bacteriologic analysis of infected human bites in patients presenting to emergency departments. Clin Infect Dis 2003; 37: 1481-9.
Notas de autor
flaviamalfa@hotmail.com